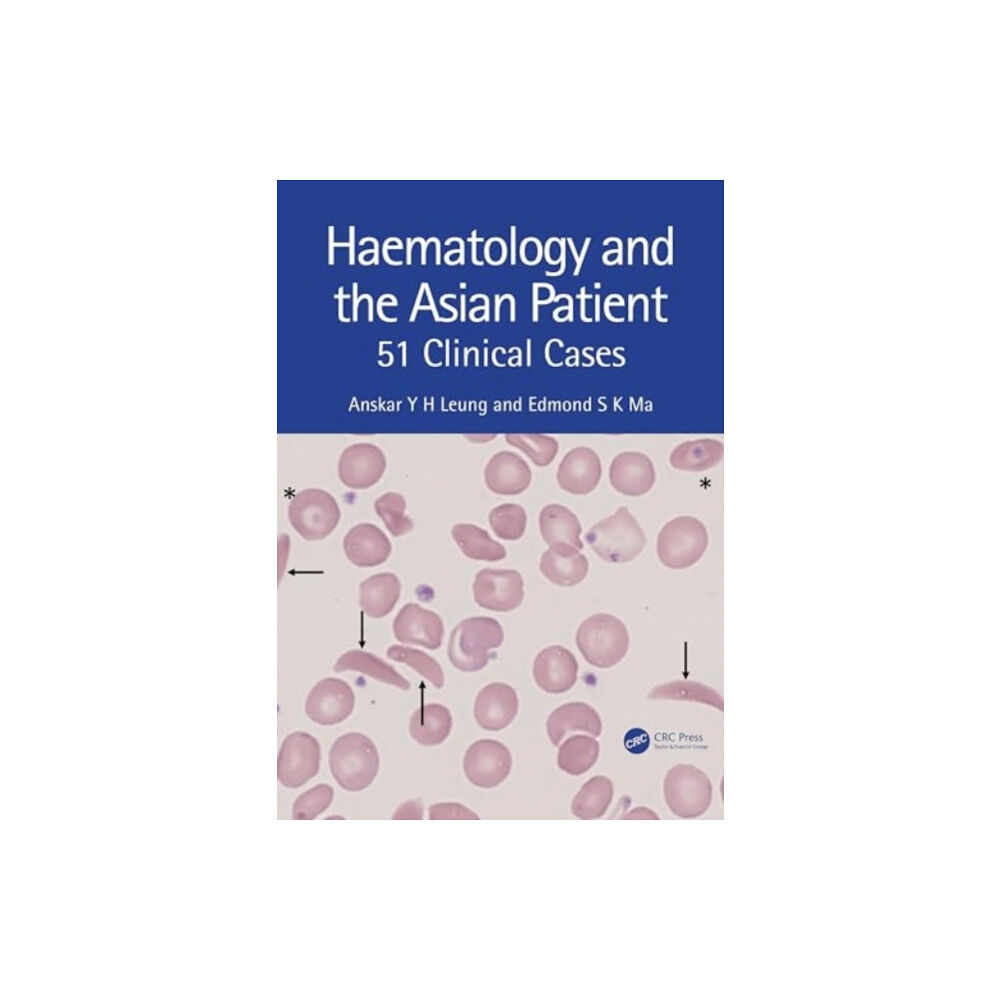
Taylor & francis ltd Haematology and the Asian Patient (häftad, eng)

Haematology encompasses a broad range of topics ranging from common and relatively benign conditions such as iron deficiency anaemia, hereditary diseases such as thalassaemia, to haematological malignancies that are often life-threatening. Burgeoning information arising from technological advances in recent years has made these subjects particularly challenging for medical students and non-specialist medical practitioners.
This book aims to highlight the pathophysiology, clinical presentations and basic principles in the investigations and managements of haematological diseases that are prevalent in Asia. Each chapter begins with a real-case clinical scenario, followed by a set of questions and is complemented by photomicrographs, data charts and illustrations.
Readers will have a grasp of the basic knowledge in haematology and the book will be a useful reference in their academic study and clinical encounters.
| Format |
Häftad |
| Omfång |
248 sidor |
| Språk |
Engelska |
| Förlag |
Taylor & Francis Ltd |
| Utgivningsdatum |
2024-06-27 |
| ISBN |
9781032351254 |